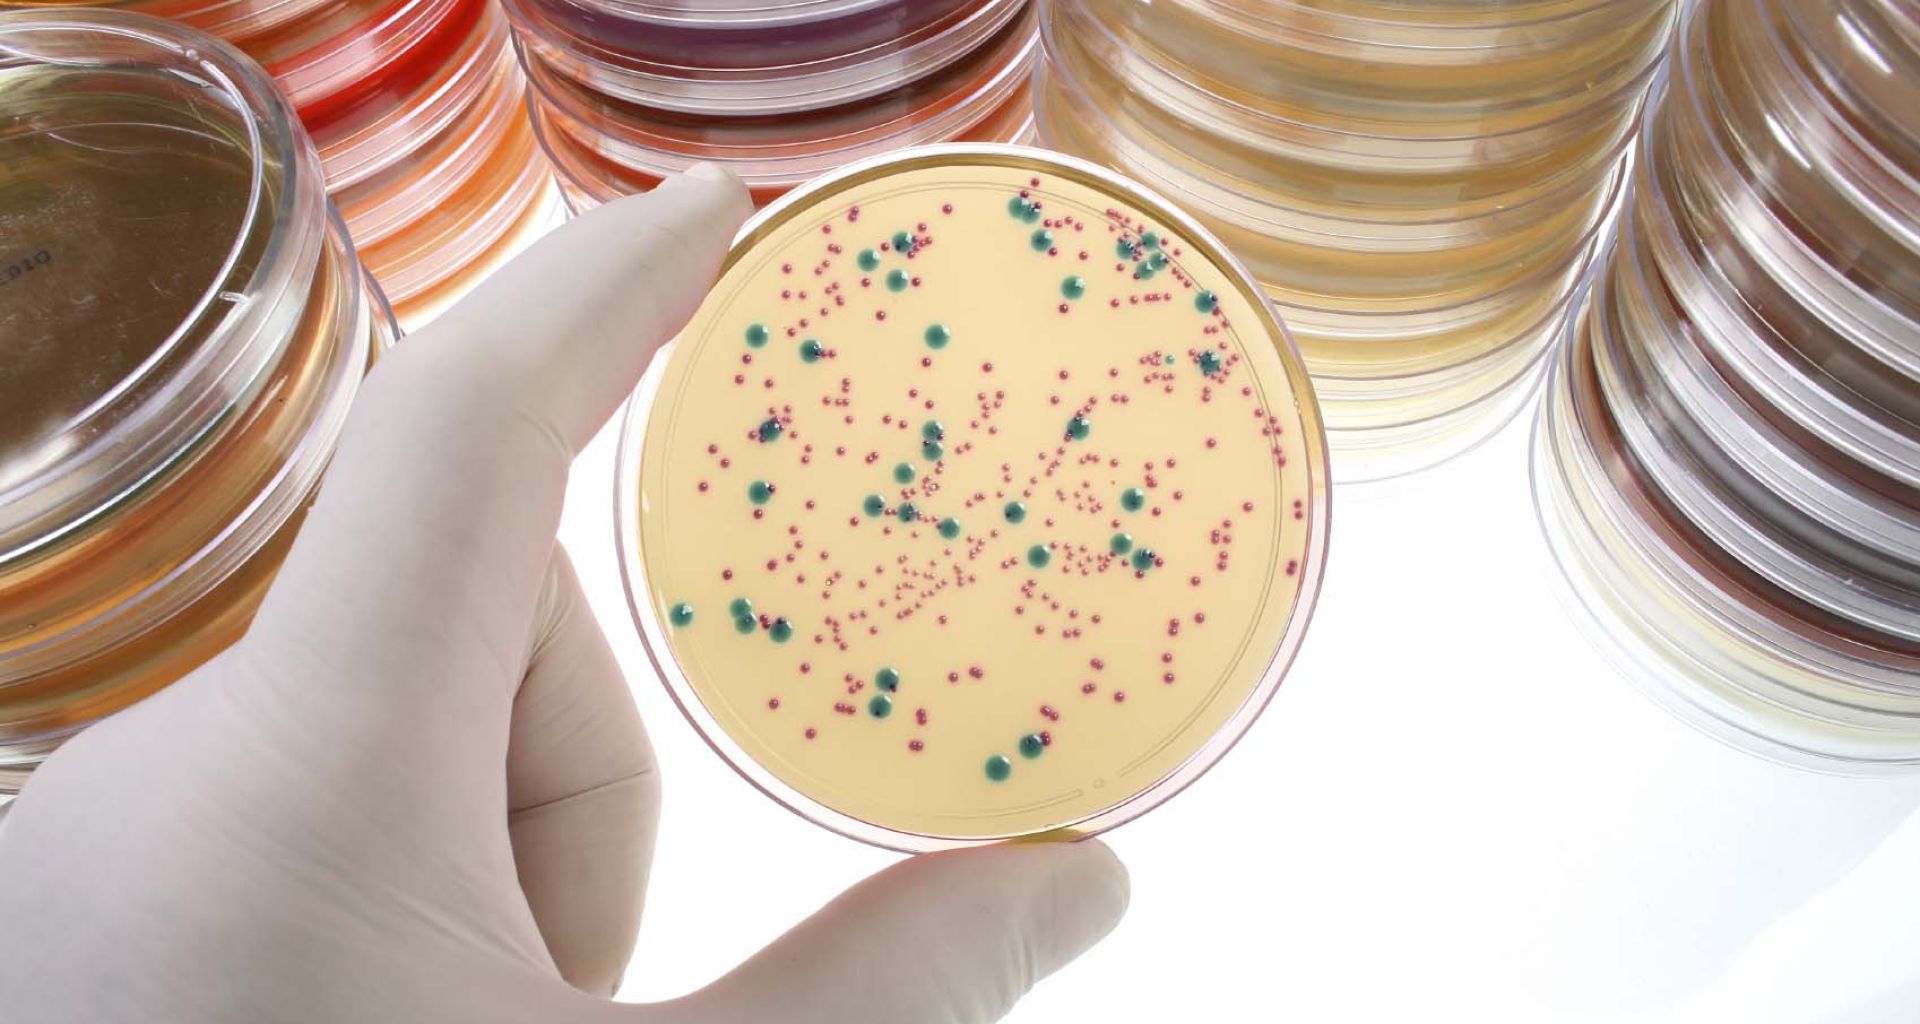
أطباق المزارع البكتيرية في معامل التحاليل الطبية بمدينة طرابلس- ليبيا. 1 أطباق المزارع البكتيرية في معامل التحاليل الطبية بمدينة طرابلس- ليبيا.

أطباق المزارع البكتيرية في معامل التحاليل الطبية بمدينة طرابلس- ليبيا.
تنتج معامل التحاليل الطبية كمية كبيرة من النفايات المعدية في شكل أطباق المزارع البكتيرية في معمل الأحياء الدقيقة، وهي شديدة العدوى إذا لم يتم التعامل معها ومعالجتها والتخلص منها بالطرق السليمة وخطورتها للعاملين والبيئة والمجتمع المحيط كبير جدا، في هذه المقالة نشرح الطريقة الني تتعامل معها معامل التحاليل الطبية في مدينة طرابلس من هذا النوع من النفايات الخطيرة
Bacterial Cultures in Clinical Laboratories in Tripoli, Libya
تعتبر معامل التحاليل الطبية (Clinical Laboratories) من ضمن المرافق الصحية المهمة والضرورية في مجال الصحة لأهمية الخذمات التي تقدمها في تشخيص الأمراض الطبية ومعرفة مسببات المرض بحيث يتمكن الأطباء من معالجة المريض وشفاءه في أسرع وقت.

من ضمن الأقسام المهمة في معامل التحاليل الطبية معمل الأحياء الدقيقة (Microbiology Laboratories) فمن خلاله يتم التعرف على الميكروبات الممرضة المسببه للألتهابات والموجودة في العينات التي تأتي من المرضى كعينات بول أو براز أو عينات المسحات القطنية من الحلق والأنف والأذن والعين أو عنق الرحم أو مسحات إفرازات الجروح أو سوائل جسم المريض الأخرى.
الإجراءات التي يقوم بها إخصائي معمل الأحياء الدقيقة هي محاولة إنبات مزارع نقية من البكتيريا الممرضة والمسببة للمرض وإكثارها من العينات عبر توفير البيئة الغذائية المناسبة والظروف الملائمة مما يساعده على التعرف عليها بسهولة وتشخيص المرض وإجراء أختبارات حساسية المضادات الحيوية لها وأختيار المضاد الحيوي المناسب ضدها. كل هذه الأجراءات المعملية ينتج عنها نفايات طبية معدية من أطباق مزارع محتوية على كميات كثيفة ومركزة من مستعمرات جراثيم المرض التي تعتبر مصدر كبير قد ينقل الأمراض للأصحاء إذا لم يتم التخلص منها بالطرق السليمة.
لماذا يجب علينا التخلص السليم من أطباق المزارع البكتيرية ومعالجتها بسرعة؟
هناك عدة أسباب جوهرية لضرورة معالجة والتخلص السريع من نفايات أطباق المزارع البكتيرية والتي يفضل دائما أن تعالج في نفس المكان:
- لإحتواءها على كميات ضخمة ومركزة من ميكروبات المرض مدعومة بالغذاء المناسب الذي سيوفر لها سبل البقاء حية لفترات زمنية طويلة جدا وهي مصدر خطر كبير على العاملين بالمرافق الصحية وعمال نقل النفايات ويمكن أن تسبب أوبيئة في المجتمع المحيط إذا ما وصلت لمصادر المياه أو الغذاء.
- هناك مخاوف كثيرة في الأونة الأخيرة أن تقع النفايات الطبية المعدية من المزارع النقية والمركزة من البكتيريا الممرضة في أيدي العابثين والمتطرفين والتي ربما يستخدمونها في أغراض إجرامية أو تستعمل في تهديد مجتمعات آمنة بنشر المرض (الأرهاب البيولوجي)، وهذا ينطبق على بعض الأنواع التي يمكن أن تشكل خطر كبير كبكتيريا الجمرة الخبيثة (Anthrax ) أو بعض بكتيريا المسببة للتسمم الغذائي.
- هذه المزارع إذا مأهملت وثم التخلص منها بدون معالجة قد تتعرض إلى تغيرات بيئية قوية من حرارة شمس وأشعة بنفسجية أو ربما تلوثت بكيماويات مختلطة مع النفايات فتحدث طفرات جينية لها مما قد ينتج أنواع جديدة وخطيرة من الميكروبات تكون أكثر ضراوة من أسلافها وأكثر مقاومة للمضادات الحيوية (Multi- Drug Resistant). لكل تلك الأسباب يجب الأهتمام بالتخلص السليم من هذه الأنواع من النفايات الطبية المعدية بأسرع وقت ممكن.

ما هي الكميات المنتجة من أطباق المزارع البكتيرية كنفايات طبية في معامل التحاليل الطبية؟
في دراسة أجريتها منذ عدة سنوات مضت ولم أنشرها شملت 20 معمل للتحاليل الطبية بمدينة طرابلس في القطاعين العام والخاص لمعرفة كميات النفايات الطبية المنتجه بها وأنواعها (كما في الرسم البياني المرفق) وطرق تعامل تلك المعامل مع النفايات الطبية. كانت الكمية الأجمالية من الأطباق المزارع البكتيرية المنتجة بها والتي ترمى في أكياس القمامة السوداء وتعامل معاملة النفايات المنزلية حوالي 7.4 طن من الأطباق المزارع البكتيرية خلال السنة الواحدة.

الكمية المنتجة تختلف من معمل إلى أخر على حسب حجم تلك المعامل فكان مختبر مركز طرابلس الطبي هو المنتج الأكبر للأطباق المزارع البكتيرية بكمية 2574 كيلوجرام/السنة بسبب حجم تعامله الكبير في مستشفى تعليمي يضم أكثر من ألفين سرير ثم يليه المختبر المرجعي بكمية 1170 كيلوجرام وأقل الكميات كانت في مختبر تحاليل طبية خاص صغير الحجم (مختبر الطبي أنجيلة) بحوالي 8 كيلوجرام/ السنة.
ولأنه لا يوجد نظام فرز النفايات الطبية (System of segregation) في كل معامل التحاليل الطبية التي أجريت عليهم الدراسة فهذه الكمية الضخمة (7.4 طن/السنة) من الأطباق المزارع البكتيرية تختلط في النهاية بعد جمعها مع كل انواع النفايات الطبية الأخرى المنتجة في تلك المعامل وهي تقدر بوزن أجمالي بـ 150 طن/السنة. وهذا يبين حجم وضخامة الضرر التي ستلحقه هذه النفايات في المجتمع إذا ما عرفنا أن الطريق المتبعة للتخلص النهائي هي الرمي العشوائي في المكبات العامة.
بعض أنواع البكتيريا قد تسبب المرض بأعداد قليلة جدا من البكتيريا مثل عصيات بكتيريا السل (Mycobacterium tuberculosis) التي يمكن لعشرة عصيات فقط منها أن تسبب المرض. وقطرة ماء واحدة محتوية على بكتيربا العصوية (Pseudomonas aeruginosa) ترمى في حوض سباحة كفيلة لإصابة كل من يسبح في الحوض وقتها بالتهابات الأذن الخارجية، وهكذا مع الأنواع الأخرى والتي ربما تختلف عن بعضها في جرعة العدوى فقط (Dose of Infection)، ونفايات الأطباق المزارع البكتيرية توفر الجرعة سواء أكانت أعداد كبيرة أو صغيرة من الميكروب.
كيف يتم التعامل مع نفايات الطبية من الأطباق المزارع البكتيرية في معامل التحاليل الطبية في مدينة طرابلس
- لوحظ أنعدام كامل لوجود إدارة النفايات الطبية في معظم معامل التحاليل الطبية من حيث الجمع والنقل والمعالجة والتخلص النهائي، كما لا يوجد نظام فرز النفايات الخطرة من أطباق المزارع البكتيرية عن النفايات الأخرى.
- تجمع النفايات الطبية من أطباق المزارع البكتيرية الناتجة من 18 معمل في أكياس سوداء وتعامل كما يتم التعامل من النفايات المنزلية بنقلها بواسطة شاحنات القمامة الخاصة بنفايات البلدية وتنتهى في المكب العام وهو مكب عشوائي وغير صحي (Dump Site).
- لوحظ من خلال الزيارات أن معمل واحد فقط (مختبر دار الوفاء للأستشفاء) يقوم بمعالجة المبدئية للأطباق المزارع البكتيرية بتعقيمها بالاوتوكليف قبل التخلص منها مع النفايات العامة للبلدية.
- معمل واحد فقط (مختبر مستشفى الحوادث أبوسليم) يقوم بنقل نفاياته الطبية إلى محرقة المستشفى ليتم التخلص منها بواسطة الحرق داخل المستشفى.
- لا توجد أي إجراءات أو لوائح أو قوانين من الجهات المختصة بالدولة أو وزارة الصحة الليبية تنظم التعامل مع النفايات الطبية في معامل التحاليل الطبية، فكل معمل طبي يتصرف من تلقى نفسه في عملية التخلص من أطباق المزارع البكتيرية ومن النفايات الطبية الأخرى.
- لا توجد أي معلومات عن الكميات المنتجة من النفايات في معامل التحاليل الطبية (Quantities Recording) ولا توجد سجلات تبين ذلك في القطاع العام أو الخاص.
- معظم معامل التحايل الطبية وخاصة في القطاع الخاص لا توجد لديهم اماكن آمنة لتخزين النفايات الطبية من الأطباق المزارع البكتيرية (Unsuitable Building Design) بل يقومون بوضع أكياس القمامة على جوانب الطريق والشوارع الرئيسية وأمام المعامل عرضة للمارة والعابثين.

الصورة: نفايات أطباق المزارع البكتيرية مرمية في أكياس القمامة السوداء ويتم التعامل معها والتخلص منها كالنفايات المنزلية .
وأخيرا، معامل التحاليل الطبية التي أجريت عليها الدراسة محتاجة لإجراءات تنظيم صارمة من قبل الدولة (وخاصة في القطاع الخاص) على كيفية التعامل مع النفايات الطبية الخطرة لهذا يجب تفعيل اللائحة التفصيلية لأدارة النفايات الطبية الليبية لسنة 2008 التي أصدرتها الهيئة العامة للبيئة وصدقت عليها وزارة الصحة.
اترك تعليقاً